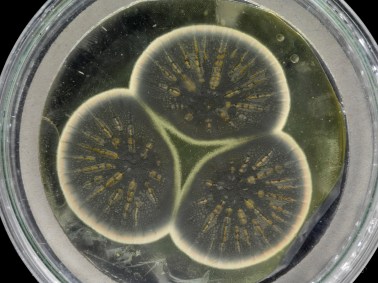

Cientistas sequenciam o DNA de mofo que produziu o primeiro antibiótico
Novas descobertas sobre o fungo conservado por 92 anos podem ajudar no combate à resistência bacteriana
A descoberta acidental da penicilina por Alexander Fleming em 1928, quando um tipo de mofo contaminou uma de suas placas de Petri, mudou os rumos da medicina moderna, tornando os antibióticos a chave para o declínio de muitas doenças através do século 20.
Agora, cientistas reviveram os fungos Penicillium originais encontrados por Fleming e sequenciaram seu genoma pela primeira vez. Eles dizem que as informações que encontraram podem ajudar na luta contra a resistência a antibióticos.
“Depois de todo esse tempo no congelador, o bolor cresce de forma relativamente rápida. É até que fácil ‘reanimá-lo’, é só tirá-lo dos tubos congelados, colocá-lo em placas de Petri, e lá vai ele”, disse Tim Barraclough, professor do Departamento de Ciências da Vida na Imperial College de Londres e do Departamento de Zoologia da Universidade de Oxford.
Leia também:
Estoques de vacinas caem até 40% no Brasil, diz associação
Vacina para Covid-19 deve ser obrigatória no Brasil, defende Doria
“Percebemos que, para a nossa surpresa, ninguém havia sequenciado o genoma do Penicillium original, apesar de sua importância histórica para o ramo”.

Fleming descobriu a penicilina em 1928, enquanto trabalhava no hospital da Escola de Medicina St. Mary, a qual agora é parte da Imperial College.
A equipe de pesquisa reproduziu o fungo Penicillium original de uma amostra congelada da coleção de culturas da CABI, organização sem fins lucrativos que trabalha com biologia, que possui mais de 30 mil cepas de microorganismos, e extraíram o DNA para fazer o sequenciamento. O bolor estava guardado em um congelador desde 1945.
Não é a primeira vez que o musgo foi cultivado de novo. Em 2019, um fungo Penicillium cultivado a partir da cepa original foi levado em uma turnê educacional na China e na Índia.
Batalha contra os ‘supermicróbios’

A equipe usou a informação genética para comparar o mofo de Fleming com duas outras cepas de Penicillium dos Estados Unidos, que são usados para produzir antibióticos em escala industrial.
Eles observaram dois tipos de genes: aqueles que codificam as enzimas que os fungos usam para produzir a penicilina; e aqueles que regulam as enzimas, por exemplo controlando quantas enzimas são produzidas. O estudo foi publicado na quinta-feira (24) na revista Scientific Reports.
Barraclough disse que eles estavam procurando por diferenças que tenham se desenvolvido naturalmente com o tempo que pudessem esclarecer como a produção de antibióticos pode ser modificada para ajudar na batalha contra as ‘supermicróbios’
“Isso pode nos dar algumas sugestões de como nós poderíamos tentar melhorar o uso ou a formulação dos antibióticos para que combatam mais bactérias”, ele disse.
“Muitos esforços estão direcionados em procurar novos tipos de antibióticos. Mas então quando são disponibilizados para o uso, a mesma coisa ocorre após um determinado tempo - entre cinco a dez anos cria-se resistência a eles”, ele acrescentou.
Sua equipe estava “procurando variações mais sutis em tipos de antibióticos e como elas podem variar na natureza, e se nós podemos usar essas diferenças sutis para combater essas bactérias”.
No início, Fleming teve dificuldades em identificar a cepa exata do fungo que criava a área “anti-bactéria” em sua placa de Petri, e ao longo dos anos, foi descoberto que muitas variações do Penicillium produzem penicilina.
Nas décadas de 30 e 40, cientistas no Reino Unido e nos Estados Unidos avaliaram várias cepas para verificar se alguma poderia ser usada para produzir penicilina em massa, e estes remédios salvaram milhares de soldados feridos e civis durante a Segunda Guerra Mundial.
Durante sua vida, Fleming percebeu que sua descoberta poderia ser ameaçada pela resistência antibiótica e avisou seus perigos em sua palestra no Nobel de 1945.
“O dia em que qualquer um poderá comprar penicilina nas farmácias chegará”, ele disse. “E então há o perigo de que uma pessoa ignorante pode ingerir uma dose pequena demais e então, vai expor seus micróbios à uma quantidade não letal do medicamento, os tornando resistentes.”
A resistência a remédios deve resultar em até 10 milhões de mortes até 2050, enquanto as bactérias superam nossos medicamentos mais sofisticados.
(Texto traduzido do inglês, clique aqui para ler o original)